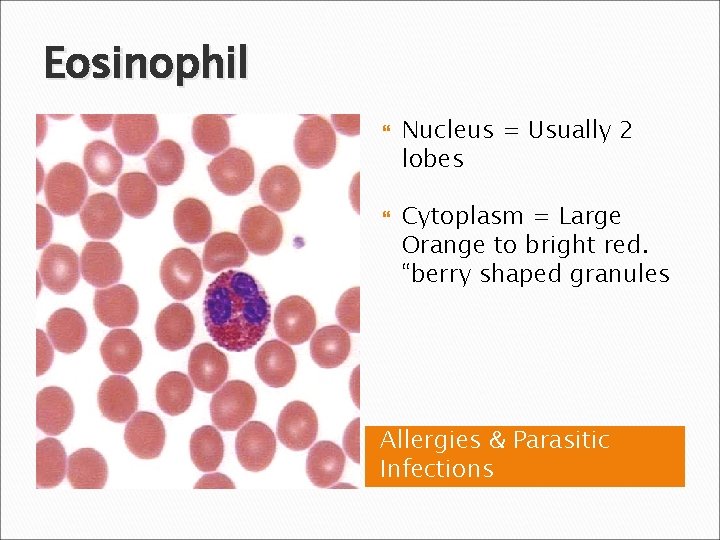
Eosinophil Nucleus = Usually 2 lobes Cytoplasm = Large Orange to bright red. “berry
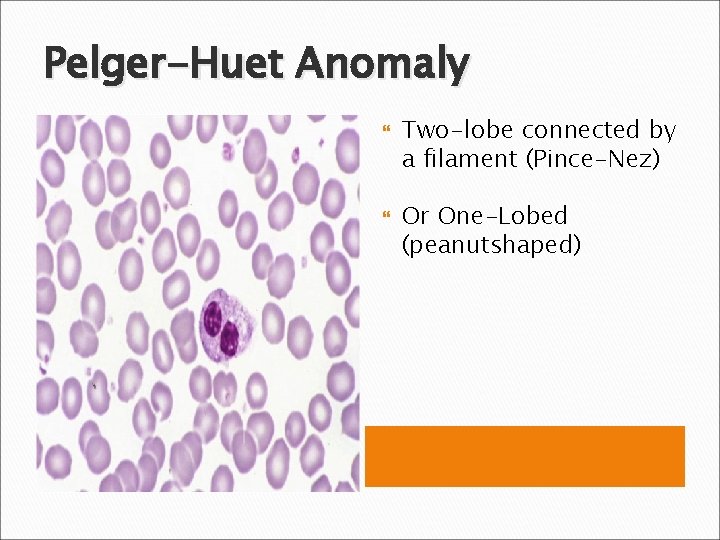
Pelger-Huet Anomaly Two-lobe connected by a filament (Pince-Nez) Or One-Lobed (peanutshaped)
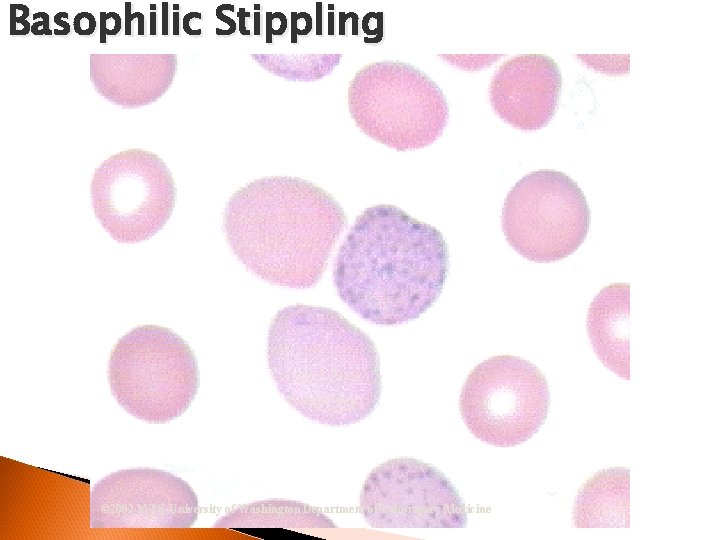
Basophilic Stippling © 2002 MTS, University of Washington Department of Laboratory Medicine

DIFFERENTIALS INTRODUCTION Given the appropriate specimens reagent and

- Slides: 91
DIFFERENTIALS INTRODUCTION
Given the appropriate specimens, reagent, and equipment, perform four of five blood cell differentials and reticulocyte counts with no more than three instructor assists. (1) (2) (3) (4) (5) (6) (7) (8) Preparation of Peripheral Blood Smears Staining Techniques Rules for Cell Maturation WBC and Platelet Morphology RBC Morphology Reticulocytes Differential WBC Count Procedure
Preparation of Peripheral Blood Smear Used to perform differential white cell count Specimen Collection ◦ Venipuncture, fingerstick or heelstick ◦ EDTA whole blood less than four hours
Making Peripheral Blood Smears Place slide on gauze Use Diff-Safe dispenser or hematocrit tube Place blood 1/3 up from frosted end Use spreader slide
Making Peripheral Blood Smears h. Hold the spreader slide at a 30º angle h. Slide back toward the opposite end of the slide h. When contact is made, the specimen will spread along the spreader slide
Push the spreader slide toward the opposite end of the slide
Making Peripheral Blood Smears http: //www. youtube. com/watch? v=JMd 2 RSc. Yu 0 M&feature=related
Criteria Feathered edge l NO lines, ridges, or holes l Length of smear - no more then 2/3 the length of the slide l Length too long - decrease specimen, increase angle l Length too short - increase specimen, decrease angle l Speed l
Staining Techniques Wright’s Stain ◦ Methyl alcohol - Fixative ◦ Methylene blue – Nucleus ◦ Eosin - Cytoplasm
Staining Techniques Modified Wright’s Stain ◦ Glycerin – Freezing RBCs ◦ Giemsa - Parasites
Stain Buffers Stains must have a p. H of 6. 4 ◦ Too acidic: RBCs appear bright red WBC nucleus appears pale blue or colorless
Stain Buffers ◦ Too alkaline: RBCs appear grey or deep blue WBCs appear very dark blueblack
Staining Methods Stain Jar – excellent for STAT specimens Automatic – excellent for large volumes
Correct Area to Read Diff © 2002 MTS, University of Washington Department of Laboratory Medicine
Direction of Diff Reading © 2002 MTS, University of Washington Department of Laboratory Medicine
Rules of Maturation Size l Cytoplasm O Percentage O Color O Granules l Nucleus - Shape l
WBC and Platelet Morphology LEUKOPOIESIS: The production of WBCs Develop Two in Bone Marrow groups of WBCs ◦ Granulocytes ◦ Agranulocytes
Maturation sequence of granulocytes Myeloblast l Promyelocyte l Metamyelocyte (Neutrophilic) l Band Neutrophil (Stab) l Segmented Neutrophil l
Myeloblast Nucleus = 4/5 of cell 2 or more nucleoli Cytoplasm = nongranular
Promyelocyte Nucleus = round/oval Occupies half or more Cytoplasm = 1 st appearance of distinct granules
Myelocyte Last stage capable of cell division Nucleus = slightly flattened on one side no nucleoli Cytoplasm = “Dawn of Neutrophilia”
Metamyelocyte Nucleus = “kidney Bean Shape” Cytoplasm
Band (Stab) Nucleus = Band or horse-shoe shaped 2 sides run parallel Cytoplasm = (secondary) Granules stain pink-tan
Segmented Neutrophil Nucleus = 2 -5 segments (lobes) connected by threadlike filaments Cytoplasm = Stains pink-tan (secondary) granules Highest % of WBC seen Bacterial Infections
Eosinophil Nucleus = Usually 2 lobes Cytoplasm = Large Orange to bright red. “berry shaped granules Allergies & Parasitic Infections
Basophil Nucleus = 2 -4 lobes Cytoplasm = Specific Purple-Black granules mask the appearance of nucleus. Allergic Reactions
Agranulocytic Series Agranulocytes are placed into three groups: ◦ Lymphocytic series Lymphocytes ◦ Monocytic series Monocyte ◦ Plasmocytic series Plamocyte
Lymphocyte 2 nd numerous cell seen Production of Antibodies Nucleus = round/oval Cytoplasm = may appear none Azurophilic Granules Viral Infections
Plasmocyte Nucleus = Eccentrically located Cytoplasm = small “tapioca-like” globules Mottled Foamy appearance B Lymphocytes Immunoglobulins
Monocyte Nucleus = “Brain-like convolutions” Cytoplasm = Blue-Gray ground glass appearance; vacuoles usually present Phagocytosis – eats microorganisms
Thrombocytes (Platelet) Important in the coagulation process Less mature stages rarely seen Maturation sequence: Abnormal ◦ Megakaryoblast Platelets ◦ Promegakaryocyte ◦ Megakaryocyte ◦ Thrombocyte Platelet Satellitism
Thrombocyte (platelet) Coagulation Process Produced directly from the cytoplasm of Megakaryocytes Round, oval, or spindle shaped Platelets
Reactive (Atypical) Lymphocyte Nucleus = Eccentrically located; Nucleoli Cytoplasm = Sky blue peripheral shading stains deeper near RBCs. May contain vacuoles and appear to flow around RBCs Infectious Mono and Hepatitis
Hypersegmentation Segmented Neutrophil Nucleus = 6 or more lobes w/ filaments Vitamin B 12 Deficiency, Folate Deficiency & Pernicious Anemia
Pelger-Huet Anomaly Two-lobe connected by a filament (Pince-Nez) Or One-Lobed (peanutshaped)
Toxic Granulation Occurs in neutrophillic metamyelocytes, bands, and segs Granules stain blueblack in color Acute Infections, Drug Poisoning, and Burns
Dohle Bodies Cytoplasm = Blue or Grayish “clouds” in neutrophils Bacterial Infections
Auer Rods Cytoplasm = Cigar or Rod-shaped bodies stain reddish-purple color Found in Myeloblast and Promyelocyte also in Monocytes
Smudge / Basket Cell Formed during blood smear prep Normal in small numbers
Vacuolated Giant Platelet
Erythrocytic Maturation Sequence Prorubricyte Rubricyte Metarubricyte (n. RBC) Diffusely basophilic erythrocyte (polychromatophilic erythrocyte or Reticulocyte) Erythrocyte/Mature RBC © 2002 MTS, University of Washington Department of Laboratory Medicine Rubriblast
RBC Morphological Variations Anisocytosis: Any variation in size outside the normal RBC diameter. Microcytosis (microcytes) Macrocytosis (macrocytes)
RBC Morphological Variations Poikilocytosis: Major deviation from normal shape ◦ Sickle cells ◦ Spherocytes ◦ Ovalocytes/Elliptocytes ◦ Target cells (codocytes) ◦ Helmet cells (schistocytes) ◦ Burr cells ◦ Acanthocytes ◦ Crenated RBCs ◦ Tear drop cells
RBC Morphological Variations Hypochromia ◦ Enlarged central zone of pallor Polychromatophilia ◦ Larger than mature RBC ◦ Stains pink-blue
RBC Morphological Variations • Inclusions: Howell-Jolly Bodies DNA Basophilic Stippling RNA Cabot Rings Malarial Gametocytes Parasites Hgb C Crystals Hemoglobin Crystals Pappenheimer Bodies
Malaria Cabot Ring Figure-eight like beads of a necklace
3 c. Using the procedure, specimens, reagents, and equipment, perform three blood cell differentials with no more than four instructor assists.
Examination of blood smear Quantitative and qualitative analysis of WBCs Semi-quantitative and qualitative analysis of platelets Evaluation of the morphological characteristics of RBCs
Evaluate RBC Morphology Examine at least 5 oil immersion fields for size, shape, color, NRBCs and inclusions N/N ◦ Normochromic/normocytic ◦ Hypochromia Hypochromic ◦ Anisocytosis ◦ Poikilocytosis ◦ Immature cells Metarubricyte
Reporting Percentage of Cells l Slight: 25% l Moderate: 50% l Marked: > 75%
Platelet Estimation 0 -6 platelets/oil immersion field ◦ Report as decreased 7 -20 platelets/oil immersion field ◦ Report as adequate >20 platelets/oil immersion field ◦ Report as increased
Normal Values Segmented neutrophil: Lymphocyte: Basophil: Eosinophil: Monocyte: Band neutrophil: Immature: 55 -65% 20 -35% 0 -1% 2 -4% 2 -6% 3 -7% 0 -1%
3 d. Using the procedure, specimens, reagents, and equipment, perform reticulocyte counts with no more than four instructor assists.
Principle Non-nucleated immature RBCs retain traces of remnant RNA Supravital staining ◦ substance appears as chain-like reticulum # of retics counted per 1000 RBCs ◦ expressed as a percentage
Calculations % Reticulocytes = Total # retics per 1000 RBCs 10
Sources of Error Evaluating less than 1, 000 RBCs Evaluating more than 1000 RBCs Confusion with RBC inclusions Failure to remix after incubation Incorrect stain: blood ratio Use of heparinized whole blood
3 a. Using the procedure, specimens, and equipment, prepare two peripheral blood smears with a feathered edge covering one-half to two-thirds the length of the microscope slide. (1) Preparation of Peripheral Blood Smears (2) Staining Techniques
3 b. Using no reference and visual aids provided, perform blood cell differential with a minimum of 70% accuracy. (1) (2) (3) (4) Rules for Cell Maturation WBC and Platelet Morphology Red Blood Cell Morphology Reticulocytes
3 c. Using the procedure, specimens, reagents, and equipment, perform blood cell differentials with no more than four instructor assists. (1) Differential White Blood Cell Count (2) Normal Values
3 d. Using the procedure, specimens, reagents, and equipment, perform reticulocyte counts with no more than four instructor assists. (1) (2) (3) (4) (5) (6) (7) (8) Clinical Significance Principle Equipment, Reagents, and Supplies Procedure Calculations Normal Values Sources of Error ORM Group Discussion
Hypochromasia © 2002 MTS, University of Washington Department of Laboratory Medicine
Spherocytosis © 2002 MTS, University of Washington Department of Laboratory Medicine
Spherocytosis © 2002 MTS, University of Washington Department of Laboratory Medicine
Teardrop Cells © 2002 MTS, University of Washington Department of Laboratory Medicine
Target Cells © 2002 MTS, University of Washington Department of Laboratory Medicine
Stomatocytes © 2002 MTS, University of Washington Department of Laboratory Medicine
Sickle Cells © 2002 MTS, University of Washington Department of Laboratory Medicine
Basophilic Stippling © 2002 MTS, University of Washington Department of Laboratory Medicine
Reactive Lymphocyte © 2002 MTS, University of Washington Department of Laboratory Medicine
Reactive Lymphocyte © 2002 MTS, University of Washington Department of Laboratory Medicine
Poikilocytosis © 2002 MTS, University of Washington Department of Laboratory Medicine
Poikilocytosis/Schistocytes © 2002 MTS, University of Washington Department of Laboratory Medicine
Abnormal Platelets © 2002 MTS, University of Washington Department of Laboratory Medicine
Platelet Satellitism © 2002 MTS, University of Washington Department of Laboratory Medicine
Plasmocyte © 2002 MTS, University of Washington Department of Laboratory Medicine
Metarubricyte © 2002 MTS, University of Washington Department of Laboratory Medicine
Normochromic/Normocytic © 2002 MTS, University of Washington Department of Laboratory Medicine
Monocyte © 2002 MTS, University of Washington Department of Laboratory Medicine
Lymphocytes © 2002 MTS, University of Washington Department of Laboratory Medicine
Hypochromasia © 2002 MTS, University of Washington Department of Laboratory Medicine
Hypersegmentation © 2002 MTS, University of Washington Department of Laboratory Medicine
Hypersegmentation © 2002 MTS, University of Washington Department of Laboratory Medicine
Ovalocyte © 2002 MTS, University of Washington Department of Laboratory Medicine
Macrocytes © 2002 MTS, University of Washington Department of Laboratory Medicine
Burr Cells © 2002 MTS, University of Washington Department of Laboratory Medicine
Howell-Jolly Bodies © 2002 MTS, University of Washington Department of Laboratory Medicine
Target Cells/Metarubricyte © 2002 MTS, University of Washington Department of Laboratory Medicine
Polychromatophilic/Diffusely Basophilic RBC © 2002 MTS, University of Washington Department of Laboratory Medicine
Malarial Gametocytes © 2002 MTS, University of Washington Department of Laboratory Medicine
Hgb C Crystals © 2002 MTS, University of Washington Department of Laboratory Medicine
Retic and Heinz Bodies © 2002 MTS, University of Washington Department of Laboratory Medicine